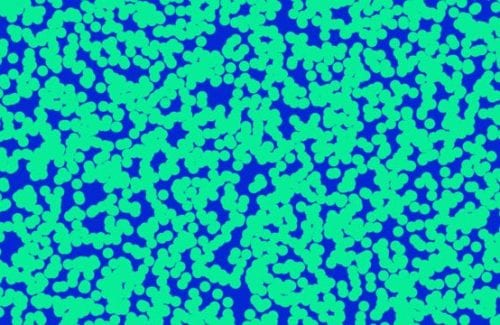

UsefulFX Toolkit
スパークルやストリーク、ディストーション、バックグラウンドパターンなど様々なツールを収録するFinal Cut Pro専用プラグイン
スパークルやストリーク、ディストーション、バックグラウンドパターンなど様々なツールを収録するFinal Cut Pro専用プラグイン
UsefulFX Toolkitは、スパークルやストリーク、ディストーション、バックグラウンドパターンなど様々なツールを収録するFinal Cut Pro X専用プラグインです。
プラグインをインストールするとFinal Cut Pro XのタイトルブラウザとジェネレーターブラウザにUsefulFX Toolkitフォルダが生成されプラグインが格納されます。タイトルブラウザに収録される各プラグインはテーマごとに分類され、テキスト、イメージなどに適用することができます。ジェネレーターブラウザに収録されるプラグインはバックグラウンド生成に最適です。エフェクトやユーティリティ―ツール、バックグラウンド生成まで幅広い効果を網羅するUsefulFX Toolkitをご利用ください。

※最新の FxFactory Pro のインストーラーにてご利用ください。
※Windowsはサポート対象外、macOSでのみ利用することができます。
上記の【FxFactoryインストーラー】ボタンをクリックするとFxFactoryのダウンロードページが開きます。DownloadボタンをクリックしてFxFactoryのインストーラーをダウンロードしてください。

FXFACTORY プラグインファミリー製品インストール方法
インストーラーはNoise Industries 社【FxFactory】のインストーラーに収録されています。製品のインストーラーは、デモ版、正規版を兼用します。正規ライセンスの認証を行わない場合、デモ版(画面に透かしが表示されます)として製品の全機能をお試し頂けます。
レトロな雰囲気を演出する30種類のスタイライズツールを収録!フリッカーやライトリーク、アナグリフエフェクト収録のFCPプラグイン

YouTubeに特化した82種類のタイトルとトランジションを収録するFinal Cut Pro X専用のプラグイン

レンズフレアやカラーフィルター、補正、コールアウトなど97種類のユーティリティツールを収録するFinal Cut Pro専用プラグイン

YouTubeなど、SNS向けの映像制作に最適な60種類のツールを収録するFinal Cut Pro専用プラグイン
